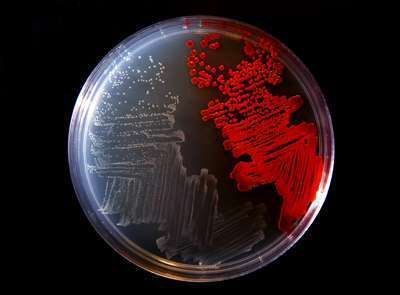
A culture plate shows the colorless bacterium Serratia marcescens strain sicaria (left) and another type of bacteria (right). Photo: University of Wisconsin-Stout

Photo: University of Wisconsin-Stout
Bees can’t seem to catch a break. A University of Wisconsin-Stout biology professor and his students have identified a new bacterium that may be part of the reason why so many hives die during the winter.
Professor and longtime beekeeper Jim Burritt and his students discovered the new strain of the bacterium, Serratia marcescens, while studying blood drawn from sick bees in Dunn County, Wisconsin.
“It was clear we were looking at something different,” Burritt told UW-Stout. “As we did more testing on the organism, we began to realize that we may be working with a new threat to honeybees. We then collaborated with experts in bacterial genetics and biochemistry at the University of Wisconsin-Madison, who used mass spectrometry and three independent, whole genome methods to confirm this organism had not been previously described in literature.”
The strain has been named sicaria, which means assassin, due to its killing power. It’s called Ss1 for short.
“Our results indicate that Ss1 may contribute to the wintertime failure of honeybee colonies,” Burritt said. “We believe this is important because most beekeepers in our area lose over half of their hives each winter. In Dunn County, the percentage of winter hive failure rates has been as high as 80 percent recently.”
To study the prevalence of the new disease, beekeepers from Wisconsin and Minnesota provided samples from 91 hives for testing.
Of the 3,219 honeybees and 1,259 varroa mites tested from December 2014 to September 2016, Ss1 was found in bees and mites from every participating county.
Burritt and his students found that 48 percent of the hives sampled for bees tested positive for the disease, including a package of bees shipped from another region of the country. The hives sampled for mites had 76 percent test positive. Of the hives that died over the winter, 73 percent had Ss1 present.
This study revealed that varroa mites could carry the Ss1 bacterium; previously, it was only known they could carry viruses. Researchers also found that Ss1 has 65 genes not found in other strains of Serratia, meaning it has been borrowing genetic information from other bacteria.
It may seem like bad news, but the discovery will now allow researchers to focus on finding a solution to the bacteria.
“Though our study does not provide information on how winterkill can be stopped, we believe it will create a clearer picture of the diseases and challenges that honeybees face,” Burritt said. “This view will be important in eventually developing strategies to help bees survive the long months of winter.”